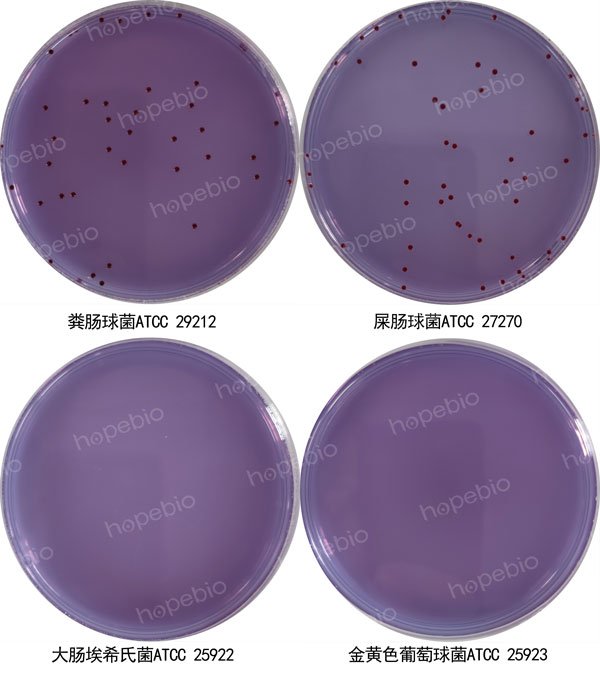

屎肠球菌选择性培养基/用于屎肠球菌的选择性分离培养
-
MH液体试管
BNCC391763 | 见详情
-
中国蓝培养基即用型平板
BNCC391618 | 见详情
-
肉汤培养基G(麦康凯肉汤)
BNCC391158 | 见详情
-
EG肉汤培养基
BNCC390941 | 见详情
-
蛋白瘤胃球菌培养基基础(含纤维二糖)
BNCC389132 | 见详情



用途:用于屎肠球菌的选择性分离培养。
原理:胰蛋白胨和酵母浸粉作为营养物质提供菌体细胞生长所需要的氮源、维生素、氨基酸及生长因子等;葡萄糖提供菌体细胞生长所需要的碳源;磷酸盐为菌体生长提供相对稳定的酸碱缓冲体系;溴甲酚紫是酸碱指示剂,酸性呈黄色,碱性呈紫色;叠氮化钠抑制革兰氏阴性菌的细胞色素氧化酶,从而抑制革兰氏阴性菌的生长;2,3,5-氯化三苯四氮唑可作为氧化还原指示剂,细菌进行还原反应后,被染上不同程度的红色从而形成红色菌落;琼脂是培养基的凝固剂。
成分(g/L)称取本品55.52g,加热搅拌煮沸,完全溶解于1000ml蒸馏水中,冷至50℃左右时,倾入无菌平皿备用。
屎肠球菌选择性培养基微生物质控结果
屎肠球菌选择性培养基微生物灵敏度试验:按标签用法制备培养基,接种以下质控菌株,放置36±1℃需氧培养24-48小时。注:回收率计算时,用TSA琼脂做对照培养基。
以上信息仅供参考,请以实物批次为准!
本公司销售的所有产品仅供实验科研使用,不用于人体及临床诊断。
2. 选择性培养:使用含叠氮化钠的胆汁七叶苷琼脂;
3. 生化鉴定:包括6.5% NaCl耐受性、麦芽糖发酵等[7]。
以上信息仅供参考,请以相应标准的原文为准!